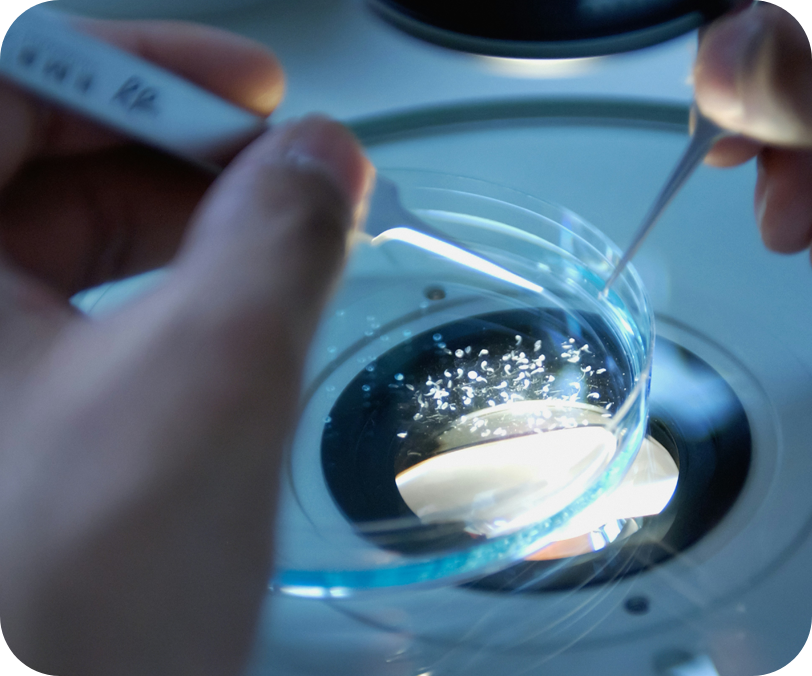

R&D : Specialty materials and chemicals
Our state-of-the-art process and analytical lab in Navi Mumbai spans 17,000 sq. ft. across four floors. It is equipped with 21 fume hoods, dedicated analytical infrastructure, and a cleanroom for handling electronic and performance materials. The facility houses cutting-edge analytical instruments to support advanced research and development.
Bio-Chemicals
Our biotech arm, Shreenika, based in San Diego, USA, leverages a synthetic biology platform to enable greener manufacturing with low carbon emissions and minimal environmental impact. Using renewable feedstocks such as sugars, biomass, and waste products, we can create a wide range of sustainable chemicals.

Flow Chemistry
Flow chemistry enables continuous chemical processing, offering advantages such as enhanced safety, precise control, automation, and efficient heat and mass transfer. At Samnan, we have successfully executed several complex chemistries, including:
- Diazotization reactions
- Gas-liquid chlorination
- Pyrophoric reactions
- Bromination, cyanation, condensation, amination, and more.
Manufacturing
We are developing a Greenfield manufacturing facility at Payal Industrial Park near Dahej, Gujarat. This large-scale production site is expected to be operational by Q1 2026, supporting our expansion into high-volume specialty chemicals and sustainable manufacturing.
